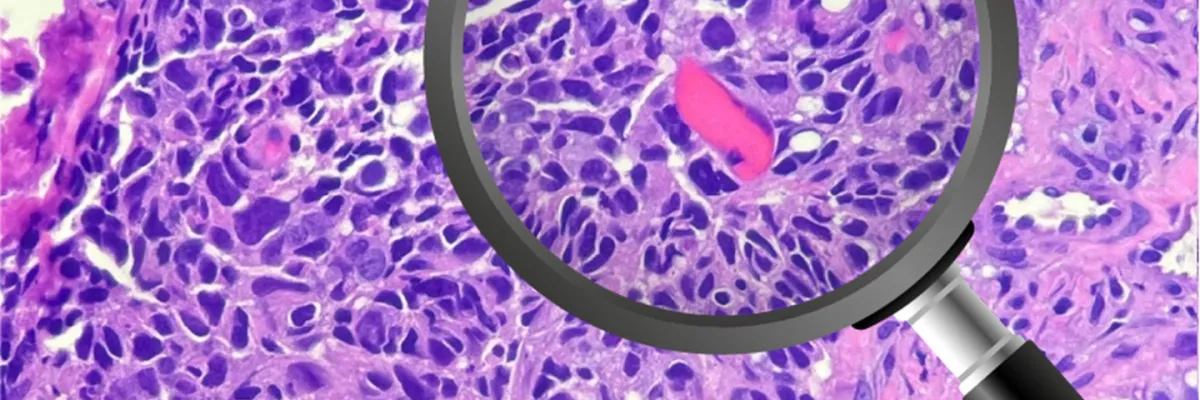
Lesiones Area Maxilofacial

Fecha
5 de Marzo de 2026
Lugar
Plataforma virtual de transmisión
Precio
$ 80.000 COP
Inscripción
Fecha de inicio:
5 de Marzo de 2026
Fecha de finalización:
5 de Marzo de 2026
Horario:
5:00 pm a 6:00 pm
Especialidad:
Dirigido a:
Odontólogos, Cirujanos Maxilofaciales, Cirugía Bucal y Patología
Organiza:
Departamento de Salud Oral
Patrocina:
Educación y Gestión del Conocimiento
Información adicional
Para más información:
inscripciones@fsfb.edu.co - 6016030303 Ext. 5749 y 5725
Información importante:
- Este es un evento virtual
- Inscripción: $80.000 COP
(Pago en línea, transferencia o consignación)
- Inscríbete en el link de la parte superior de la imagen que dice inscripción
Formas de pago:
- Pago en línea: Regístrese en esta página y realice el pago con tarjeta débito o crédito.
- Pago en sucursal bancaria: Realizar consignación en la cuenta de ahorros de recaudo Bancolombia No. 172226552-34 y convenio No. 64460, a nombre de Fundación Santa Fe de Bogotá (por favor proporcionar número de identificación de quien va a tomar o asistir al curso, o el NIT de la empresa que hace el pago). Si consigna fuera de Bogotá, por favor incluir el valor de consignación nacional.
- Transferencia bancaria: Cuenta de ahorros de recaudo Bancolombia No. 172226552-34 a nombre de Fundación Santa Fe de Bogotá, NIT 860037950-2 y convenio No. 64460. (por favor proporcionar número de identificación de quien va a tomar o asistir al curso, o el NIT de la empresa que hace el pago).
Para formalizar su inscripción tenga en cuenta las siguientes recomendaciones:
Enviar soporte de pago al correo inscripciones@fsfb.edu.co con los datos de la(s) persona(s) que va(n) a tomar el curso (nombre, cédula o ID, ciudad, dirección, teléfono, correo, profesión e institucion donde trabaja o estudia)
Eventos que te podrían interesar
Para adquirir cupos para este evento, es necesario que te registres. Si ya cuentas con un registro, simplemente inicia sesión


